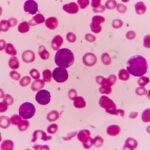
Magnitude of the Dengue Problem: Global Overview

Dengue fever currently represents a major and escalating global public health crisis, with a record-breaking number of cases and deaths reported in recent years.
Current/Recent Global Trends
- In 2024, the world saw an unprecedented surge in dengue, surpassing 14.6 million cases and recording more than 12,000 dengue-related deaths, making it the highest annual total ever documented.
- By mid-2025, over 4 million cases and more than 3,000 deaths had already been recorded from 97 countries, indicating persistently high transmission.
- Most cases occur in the Americas, Southeast Asia, and the Western Pacific. However, dengue is increasingly spreading to new areas, such as parts of Europe and the Eastern Mediterranean.
Scale and Geographic Spread
- Dengue affects over 100 countries. Recent modeling suggests that 5.6 billion people—more than half the global population—are now at risk of infection.
- The Americas contributed a significant share of the global burden in 2024 (over 13 million cases), followed by the Southeast Asia and Western Pacific regions.
Disease Burden and Impact
- Surveillance reports estimate the annual global dengue burden at around 390 million infections, of which about 96 million manifest clinically.
- Annual global dengue deaths have more than doubled from 1990 to 2021.
- Disability-Adjusted Life Years (DALYs) lost due to dengue rose from 1.25 million in 1990 to over 2 million in 2021.
- The disease imposes a substantial economic and social burden, especially in endemic countries, through hospitalization costs, loss of productivity, and strain on fragile health systems.
- The WHO estimates that by 2080, up to 63% of the entire global population could be at risk.
Key Drivers
Dengue expansion is fueled by the global distribution of its mosquito vectors like Aedes aegypti and Aedes albopictus, climate change (increasing rainfall, temperatures, and humidity), urbanization, industrialization, international travel, and labor migration, among other factors.
Summary of Global Magnitude
Dengue continues to be the fastest-growing mosquito-borne viral disease in the world, with ongoing geographic expansion, severe outbreaks, and rising morbidity and mortality. Its magnitude is a critical public health threat for the 21st century.
| Metric | 2024 | 2025 (up to Aug) | Historic Range |
| Cases Reported | 14.6 million | 4+ million | 50 million–100 million |
| Deaths | 12,000+ | 3,000+ | 14,000–30,000 |
| DALYs Lost | NA (2024) | NA | 2+ million |
| Population at Risk | 5.6 billion | — | 3–4 billion |
Magnitude of Dengue Fever in India
India faces a severe and escalating dengue fever burden, consistently ranking among the countries with the highest case loads and deaths globally. India accounts for nearly a third of the global dengue burden.
Case and Mortality Statistics
- In 2024, official figures show India reported about 233,519 dengue cases and 297 deaths.
- The highest annual case burden in recent years was in 2023, with 289,235 cases and 485 deaths—the most significant since 2019.
- For 2025 (up to August), more than 49,573 cases and 42 deaths have already been recorded as monsoon and post-monsoon peaks escalate.
- Forecasting studies predict a yearly increase, with a projected burden for 2025 ranging upward of 313,501 cases and 511 deaths.
Geographical Distribution and Hotspots
- Southern India dominates in cases: Karnataka (32,886 cases in 2024), Tamil Nadu (27,378), Maharashtra (19,385), and Kerala (20,674), with Kerala also reporting the highest number of deaths.
- Delhi, UP, and Gujarat also reported substantial outbreaks.
- Regional disparity is clear; eastern states and islands reported far fewer cases, while northern and southern cities repeatedly triggered major outbreaks during the monsoon season.
- Most cases are seen among youth and middle-aged adults, but women over fifty are at the highest risk for serious complications.
India Dengue Burden Summary
| Year | Cases | Deaths | States with Highest Burden |
| 2023 | 289,235 | 485 | Karnataka, TN, Kerala, Maharashtra |
| 2024 | 233,519 | 297 | Karnataka, TN, Kerala, Maharashtra |
| 2025 (so far) | 49,573 | 42 | Kerala, TN, Delhi, UP |
| 2025 (forecast) | 313,501 | 511 | Southern & Urban hotspots |